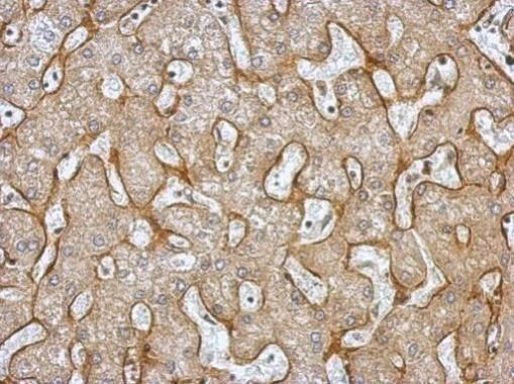
TNFR1 Antibody in Immunohistochemistry (Paraffin) (IHC (P))

Search
Invitrogen
TNFR1 Polyclonal Antibody
{{$productOrderCtrl.translations['antibody.pdp.commerceCard.promotion.promotions']}}
{{$productOrderCtrl.translations['antibody.pdp.commerceCard.promotion.viewpromo']}}
{{$productOrderCtrl.translations['antibody.pdp.commerceCard.promotion.promocode']}}: {{promo.promoCode}} {{promo.promoTitle}} {{promo.promoDescription}}. {{$productOrderCtrl.translations['antibody.pdp.commerceCard.promotion.learnmore']}}
产品信息
PA5-27766
宿主/亚型
分类
类型
抗原
偶联物
形式
浓度
保存条件
运输条件
RRID
产品详细信息
PA5-27766 targets TNF Receptor I in IHC (P) and WB applications and shows reactivity with Human samples.
The PA5-27766 immunogen is recombinant fragment corresponding to a region within amino acids 1 and 194 of Human TNF Receptor I.
靶标信息
TNFR1 (Tumor necrosis factor receptor 1) belongs to the tumor necrosis factor superfamily, and is one of the major TNF-alpha receptors. TNFR1 plays an important role in mediating, in cytokine mediated signaling, positive regulation of the NF-Kb pathway, positive regulation of angiogenesis, and negative regulation of gene expression. The extracellular domain of TNFR1 is also released into the circulatory system as soluble TNFR1 (sTNFR1). In humans, the TNFR1 gene is located on chromosome 12. Anti-apoptotic protein BCL2-associated athanogene 4 (BAG4/SODD) and adaptor proteins TRADD and TRAF2 have been shown to interact with TNFR1, and thus play regulatory roles in the signal transduction mediated by the receptor. Germline mutations of the extracellular domains of TNFR1 were found to be associated with the autosomal dominant periodic fever syndrome, and the impaired receptor clearance is thought to be a mechanism of the disease.
⚠WARNING: This product can expose you to chemicals including mercury, which is known to the State of California to cause birth defects or other reproductive harm. For more information go to www.P65Warnings.ca.gov.
仅用于科研。不用于诊断过程。未经明确授权不得转售。